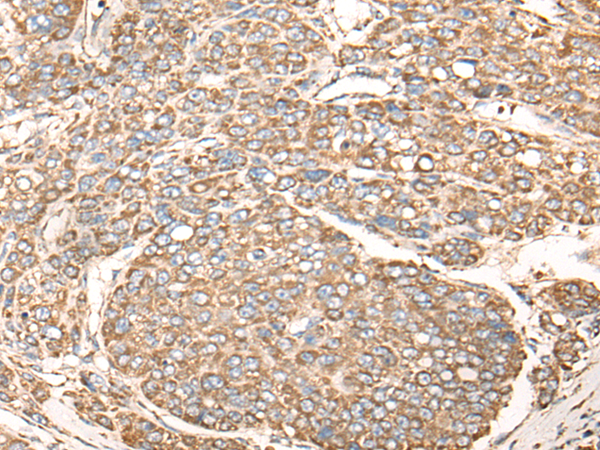
一抗

中文名稱: 兔抗NDUFB6多克隆抗體
英文名稱: Anti-NDUFB6 rabbit polyclonal antibody
別 名: CI; B17
相關(guān)類別: 一抗
儲 存: 冷凍(-20℃)
宿 主: Rabbit
抗 原: NDUFB6
反應(yīng)種屬: Human
標 記 物: Unconjugate
克隆類型: rabbit polyclonal
|
Background: |
The protein encoded by this gene is a subunit of the multisubunit NADH:ubiquinone oxidoreductase (complex I). Mammalian complex I is composed of 45 different subunits. It locates at the mitochondrial inner membrane. This protein has NADH dehydrogenase activity and oxidoreductase activity. It transfers electrons from NADH to the respiratory chain. The immediate electron acceptor for the enzyme is believed to be ubiquinone. Alternative splicing occurs at this locus and three transcript variants encoding distinct isoforms have been identified. |
|
Applications: |
ELISA, IHC |
|
Name of antibody: |
NDUFB6 |
|
Immunogen: |
Full length fusion protein |
|
Full name: |
NADH:ubiquinone oxidoreductase subunit B6 |
|
Synonyms: |
CI; B17 |
|
SwissProt: |
O95139 |
|
ELISA Recommended dilution: |
5000-10000 |
|
IHC positive control: |
Human liver cancer |
|
IHC Recommend dilution: |
25-100 |

 購物車
購物車 幫助
幫助
 021-54845833/15800441009
021-54845833/15800441009